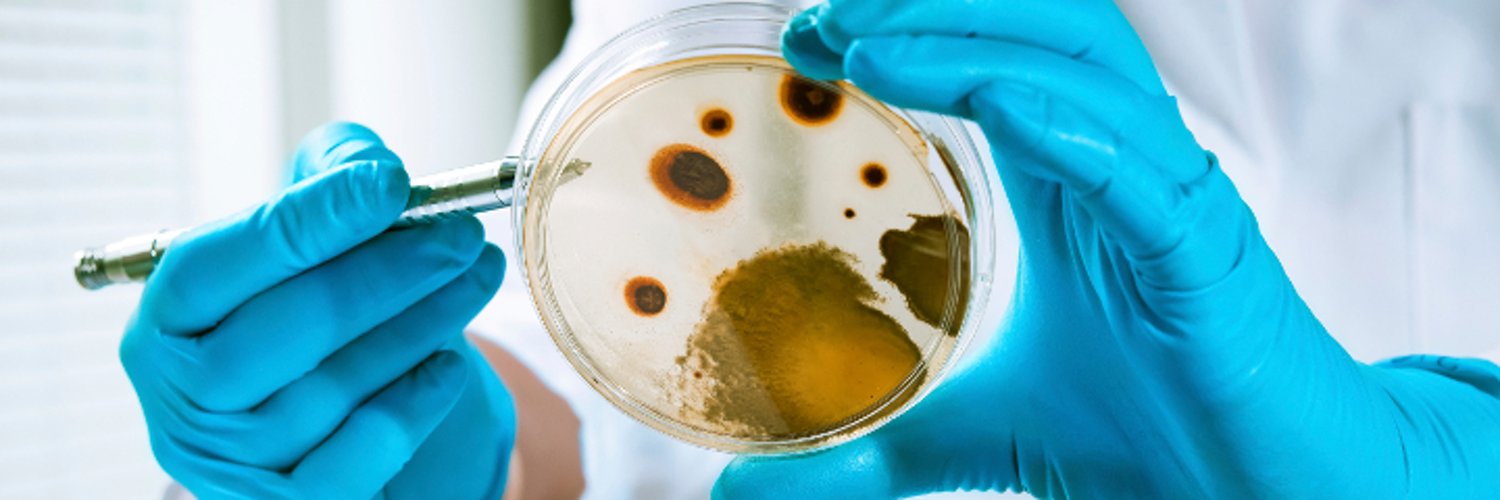

ಟ್ವೀಟ್ಗಳು
- ಟ್ವೀಟ್ಗಳು, ಪ್ರಸ್ತುತ ಪುಟ.
- ಟ್ವೀಟ್ಗಳು & ಪ್ರತಿಕ್ರಿಯೆಗಳು
- ಮಾಧ್ಯಮ
ನೀವು @IMIBirmingham ಅವರನ್ನು ತಡೆಹಿಡಿದಿರುವಿರಿ
ಈ ಟ್ವೀಟ್ಗಳನ್ನು ವೀಕ್ಷಿಸಲು ನೀವು ಖಚಿತವಾಗಿ ಬಯಸುವಿರಾ? ಟ್ವೀಟ್ ವೀಕ್ಷಣೆಯು @IMIBirmingham ಅವರ ತಡೆತೆರವುಗೊಳಿಸುವುದಿಲ್ಲ
-
Woo-hoo…what an awesome Christmas present!! Well done
@pmoyniha…bring on all of those exciting new experiments! https://twitter.com/pmoyniha/status/1075316374640168960 …ಧನ್ಯವಾದಗಳು. Twitter ಇದನ್ನು ನಿಮ್ಮ ಕಾಲರೇಖೆಯನ್ನು ಉತ್ತಮಗೊಳಿಸಲು ಬಳಸುತ್ತದೆ. ರದ್ದುಗೊಳಿಸುರದ್ದುಗೊಳಿಸು
https://twitter.com/pmoyniha/status/1075316374640168960 …ಧನ್ಯವಾದಗಳು. Twitter ಇದನ್ನು ನಿಮ್ಮ ಕಾಲರೇಖೆಯನ್ನು ಉತ್ತಮಗೊಳಿಸಲು ಬಳಸುತ್ತದೆ. ರದ್ದುಗೊಳಿಸುರದ್ದುಗೊಳಿಸು -
IMIBirmingham ಅವರು ಮರುಟ್ವೀಟಿಸಿದ್ದಾರೆ
Guys, it was supposed to be a silent disco! The last ones standing at the
@IMIBirmingham christmas party!@alanmcn1@SammiMcKeand@Jess_Gray_pic.twitter.com/KozkwlSygnಧನ್ಯವಾದಗಳು. Twitter ಇದನ್ನು ನಿಮ್ಮ ಕಾಲರೇಖೆಯನ್ನು ಉತ್ತಮಗೊಳಿಸಲು ಬಳಸುತ್ತದೆ. ರದ್ದುಗೊಳಿಸುರದ್ದುಗೊಳಿಸು -
Three days until holiday season, but the
@IMIBirmingham is finishing the year with a bang -@nrt_thomson talking cholera epidemiology in the 21st century.ಧನ್ಯವಾದಗಳು. Twitter ಇದನ್ನು ನಿಮ್ಮ ಕಾಲರೇಖೆಯನ್ನು ಉತ್ತಮಗೊಳಿಸಲು ಬಳಸುತ್ತದೆ. ರದ್ದುಗೊಳಿಸುರದ್ದುಗೊಳಿಸು -
IMIBirmingham ಅವರು ಮರುಟ್ವೀಟಿಸಿದ್ದಾರೆ
Spot your favourite
@IMIBirmingham microbiologist dancing at the Christmas Party!pic.twitter.com/EQDHiu4iHGಈ ಥ್ರೆಡ್ ತೋರಿಸಿಧನ್ಯವಾದಗಳು. Twitter ಇದನ್ನು ನಿಮ್ಮ ಕಾಲರೇಖೆಯನ್ನು ಉತ್ತಮಗೊಳಿಸಲು ಬಳಸುತ್ತದೆ. ರದ್ದುಗೊಳಿಸುರದ್ದುಗೊಳಿಸು -
The last
@IMIBirmingham Forum of 2018...@theRAD__lab discussing some plant fungi with an unhealthy appetite for eating humans...ಧನ್ಯವಾದಗಳು. Twitter ಇದನ್ನು ನಿಮ್ಮ ಕಾಲರೇಖೆಯನ್ನು ಉತ್ತಮಗೊಳಿಸಲು ಬಳಸುತ್ತದೆ. ರದ್ದುಗೊಳಿಸುರದ್ದುಗೊಳಿಸು -
Proud to support the
#MadeAtUni campaign. Discover how research at UK universities changes people’s lives:https://madeatuni.org.uk/ಧನ್ಯವಾದಗಳು. Twitter ಇದನ್ನು ನಿಮ್ಮ ಕಾಲರೇಖೆಯನ್ನು ಉತ್ತಮಗೊಳಿಸಲು ಬಳಸುತ್ತದೆ. ರದ್ದುಗೊಳಿಸುರದ್ದುಗೊಳಿಸು -
IMIBirmingham ಅವರು ಮರುಟ್ವೀಟಿಸಿದ್ದಾರೆ
Delighted to have been invited to pitch and represent
@NitroPep and@IMIBirmingham on the fight against global killers at#Innovators35EUpic.twitter.com/g8g3C9N5SX ಧನ್ಯವಾದಗಳು. Twitter ಇದನ್ನು ನಿಮ್ಮ ಕಾಲರೇಖೆಯನ್ನು ಉತ್ತಮಗೊಳಿಸಲು ಬಳಸುತ್ತದೆ. ರದ್ದುಗೊಳಿಸುರದ್ದುಗೊಳಿಸು
ಧನ್ಯವಾದಗಳು. Twitter ಇದನ್ನು ನಿಮ್ಮ ಕಾಲರೇಖೆಯನ್ನು ಉತ್ತಮಗೊಳಿಸಲು ಬಳಸುತ್ತದೆ. ರದ್ದುಗೊಳಿಸುರದ್ದುಗೊಳಿಸು -
Hidden patterns in bacterial genomes...Ling Chin Hwang is today’s
@IMIBirmingham seminar speaker, taking the stage in E102 now!ಧನ್ಯವಾದಗಳು. Twitter ಇದನ್ನು ನಿಮ್ಮ ಕಾಲರೇಖೆಯನ್ನು ಉತ್ತಮಗೊಳಿಸಲು ಬಳಸುತ್ತದೆ. ರದ್ದುಗೊಳಿಸುರದ್ದುಗೊಳಿಸು -
Yay! Congratulations Herbert!https://twitter.com/BECKS_182/status/1069665058110738433 …
ಧನ್ಯವಾದಗಳು. Twitter ಇದನ್ನು ನಿಮ್ಮ ಕಾಲರೇಖೆಯನ್ನು ಉತ್ತಮಗೊಳಿಸಲು ಬಳಸುತ್ತದೆ. ರದ್ದುಗೊಳಿಸುರದ್ದುಗೊಳಿಸು -
IMIBirmingham ಅವರು ಮರುಟ್ವೀಟಿಸಿದ್ದಾರೆ
Congratulations to
@BethGrimsey for her excellent (and award winning!) poster at the@BSACandJAC#ARM2018 meeting!!@IMIBirmingham@LauraPiddockpic.twitter.com/qKdc2uhDcp ಧನ್ಯವಾದಗಳು. Twitter ಇದನ್ನು ನಿಮ್ಮ ಕಾಲರೇಖೆಯನ್ನು ಉತ್ತಮಗೊಳಿಸಲು ಬಳಸುತ್ತದೆ. ರದ್ದುಗೊಳಿಸುರದ್ದುಗೊಳಿಸು
ಧನ್ಯವಾದಗಳು. Twitter ಇದನ್ನು ನಿಮ್ಮ ಕಾಲರೇಖೆಯನ್ನು ಉತ್ತಮಗೊಳಿಸಲು ಬಳಸುತ್ತದೆ. ರದ್ದುಗೊಳಿಸುರದ್ದುಗೊಳಿಸು -
IMIBirmingham ಅವರು ಮರುಟ್ವೀಟಿಸಿದ್ದಾರೆ
Congratulations to Professors Paulus Kirchhof and Gregory Lip from
@ICVS_UoB and Professor@LauraPiddock from@IMIBirmingham who have been recognised in@clarivate's Highly Cited Researchers 2018 https://www.birmingham.ac.uk/university/colleges/mds/news/2018/11/clarivate-highly-cited.aspx …pic.twitter.com/7YB04zcImE ಧನ್ಯವಾದಗಳು. Twitter ಇದನ್ನು ನಿಮ್ಮ ಕಾಲರೇಖೆಯನ್ನು ಉತ್ತಮಗೊಳಿಸಲು ಬಳಸುತ್ತದೆ. ರದ್ದುಗೊಳಿಸುರದ್ದುಗೊಳಿಸು
ಧನ್ಯವಾದಗಳು. Twitter ಇದನ್ನು ನಿಮ್ಮ ಕಾಲರೇಖೆಯನ್ನು ಉತ್ತಮಗೊಳಿಸಲು ಬಳಸುತ್ತದೆ. ರದ್ದುಗೊಳಿಸುರದ್ದುಗೊಳಿಸು -
IMIBirmingham ಅವರು ಮರುಟ್ವೀಟಿಸಿದ್ದಾರೆ
On my way to the
@unibirmingham for the@JAM_talks. Excited for a day filled with the excellent science of@IMIBirmingham and others!ಧನ್ಯವಾದಗಳು. Twitter ಇದನ್ನು ನಿಮ್ಮ ಕಾಲರೇಖೆಯನ್ನು ಉತ್ತಮಗೊಳಿಸಲು ಬಳಸುತ್ತದೆ. ರದ್ದುಗೊಳಿಸುರದ್ದುಗೊಳಿಸು -
IMIBirmingham ಅವರು ಮರುಟ್ವೀಟಿಸಿದ್ದಾರೆ
If you want to do a post-doc in microbial genomics with
@alanmcn1 and me@IMIBirmingham on an exciting project to map the epidemiology of multi-drug resistant bacteria in China, DM or email me. Please RT.https://twitter.com/The_MRC/status/1068062649768914944 … ಧನ್ಯವಾದಗಳು. Twitter ಇದನ್ನು ನಿಮ್ಮ ಕಾಲರೇಖೆಯನ್ನು ಉತ್ತಮಗೊಳಿಸಲು ಬಳಸುತ್ತದೆ. ರದ್ದುಗೊಳಿಸುರದ್ದುಗೊಳಿಸು
ಧನ್ಯವಾದಗಳು. Twitter ಇದನ್ನು ನಿಮ್ಮ ಕಾಲರೇಖೆಯನ್ನು ಉತ್ತಮಗೊಳಿಸಲು ಬಳಸುತ್ತದೆ. ರದ್ದುಗೊಳಿಸುರದ್ದುಗೊಳಿಸು -
Woo-hoo! Seriously BIG grant success for
@alanmcn1 and co: https://mrc.ukri.org/news/browse/uk-and-chinese-researchers-to-collaborate-on-fight-against-superbugs/ … Bravo one and all, fantastic job! ಧನ್ಯವಾದಗಳು. Twitter ಇದನ್ನು ನಿಮ್ಮ ಕಾಲರೇಖೆಯನ್ನು ಉತ್ತಮಗೊಳಿಸಲು ಬಳಸುತ್ತದೆ. ರದ್ದುಗೊಳಿಸುರದ್ದುಗೊಳಿಸು
ಧನ್ಯವಾದಗಳು. Twitter ಇದನ್ನು ನಿಮ್ಮ ಕಾಲರೇಖೆಯನ್ನು ಉತ್ತಮಗೊಳಿಸಲು ಬಳಸುತ್ತದೆ. ರದ್ದುಗೊಳಿಸುರದ್ದುಗೊಳಿಸು -
Shifts along the parasite/mutualism continuum...today’s
@IMIBirmingham seminar by@kaylacking, kicking off in E102 now!ಧನ್ಯವಾದಗಳು. Twitter ಇದನ್ನು ನಿಮ್ಮ ಕಾಲರೇಖೆಯನ್ನು ಉತ್ತಮಗೊಳಿಸಲು ಬಳಸುತ್ತದೆ. ರದ್ದುಗೊಳಿಸುರದ್ದುಗೊಳಿಸು -
Woo-hoo! Tickets for the
@IMIBirmingham Christmas Extravaganza are on sale from today…pick up yours from the IMI hub for the opportunity to see some of the finest minds in microbiology gyrating across the dance floor in Santa hats…
 ಧನ್ಯವಾದಗಳು. Twitter ಇದನ್ನು ನಿಮ್ಮ ಕಾಲರೇಖೆಯನ್ನು ಉತ್ತಮಗೊಳಿಸಲು ಬಳಸುತ್ತದೆ. ರದ್ದುಗೊಳಿಸುರದ್ದುಗೊಳಿಸು
ಧನ್ಯವಾದಗಳು. Twitter ಇದನ್ನು ನಿಮ್ಮ ಕಾಲರೇಖೆಯನ್ನು ಉತ್ತಮಗೊಳಿಸಲು ಬಳಸುತ್ತದೆ. ರದ್ದುಗೊಳಿಸುರದ್ದುಗೊಳಿಸು -
IMIBirmingham ಅವರು ಮರುಟ್ವೀಟಿಸಿದ್ದಾರೆ
"At its peak, Spanish ‘flu was killing one million people per week – the population of modern-day Birmingham." Professor
@RobinMay9 from@IMIBirmingham revisits the world's most lethal pandemic in this week's Birmingham Brief http://birmingham.ac.uk/news/thebirminghambrief/items/2018/11/spanish-flu-revisiting-the-world's-most-lethal-pandemic.aspx …pic.twitter.com/Bq8bCzPVdA ಧನ್ಯವಾದಗಳು. Twitter ಇದನ್ನು ನಿಮ್ಮ ಕಾಲರೇಖೆಯನ್ನು ಉತ್ತಮಗೊಳಿಸಲು ಬಳಸುತ್ತದೆ. ರದ್ದುಗೊಳಿಸುರದ್ದುಗೊಳಿಸು
ಧನ್ಯವಾದಗಳು. Twitter ಇದನ್ನು ನಿಮ್ಮ ಕಾಲರೇಖೆಯನ್ನು ಉತ್ತಮಗೊಳಿಸಲು ಬಳಸುತ್ತದೆ. ರದ್ದುಗೊಳಿಸುರದ್ದುಗೊಳಿಸು -
IMIBirmingham ಅವರು ಮರುಟ್ವೀಟಿಸಿದ್ದಾರೆ
Background in cell biology or fungal genetics? Looking for a postdoc? Then look no further… TWO opportunities to join
@BallouLab and me as a postdoctoral fellow@IMIBirmingham: https://www.jobs.ac.uk/job/BNV770/research-fellow … (deadline 7th Dec) https://www.jobs.ac.uk/job/BOJ953/research-fellow … (deadline 20th Dec)ಧನ್ಯವಾದಗಳು. Twitter ಇದನ್ನು ನಿಮ್ಮ ಕಾಲರೇಖೆಯನ್ನು ಉತ್ತಮಗೊಳಿಸಲು ಬಳಸುತ್ತದೆ. ರದ್ದುಗೊಳಿಸುರದ್ದುಗೊಳಿಸು -
IMIBirmingham ಅವರು ಮರುಟ್ವೀಟಿಸಿದ್ದಾರೆ
If you were wondering what its like to give a JAM talk,
@danieljmorse has written a blog post about his experience :) It was lovely to have you present your work Dan, glad you had a great time!@JAM_talkshttps://twitter.com/danieljmorse/status/1065211559570485248 …ಧನ್ಯವಾದಗಳು. Twitter ಇದನ್ನು ನಿಮ್ಮ ಕಾಲರೇಖೆಯನ್ನು ಉತ್ತಮಗೊಳಿಸಲು ಬಳಸುತ್ತದೆ. ರದ್ದುಗೊಳಿಸುರದ್ದುಗೊಳಿಸು -
Congrats to Emily Lupton, one of our undergraduates who recently won
@SpringerNature’s “Better Science through Better Data” writing competition! Read more about it here: https://researchdata.springernature.com/users/112062-warren-eades/posts/39223-announcing-this-year-s-better-science-through-better-data-scidata18-writing-competition-winners …#scidata18ಧನ್ಯವಾದಗಳು. Twitter ಇದನ್ನು ನಿಮ್ಮ ಕಾಲರೇಖೆಯನ್ನು ಉತ್ತಮಗೊಳಿಸಲು ಬಳಸುತ್ತದೆ. ರದ್ದುಗೊಳಿಸುರದ್ದುಗೊಳಿಸು
ಲೋಡಿಂಗ್ ಸಮಯ ಸ್ವಲ್ಪ ತೆಗೆದುಕೊಳ್ಳುತ್ತಿರುವಂತೆನಿಸುತ್ತದೆ.
Twitter ಸಾಮರ್ಥ್ಯ ಮೀರಿರಬಹುದು ಅಥವಾ ಕ್ಷಣಿಕವಾದ ತೊಂದರೆಯನ್ನು ಅನುಭವಿಸುತ್ತಿರಬಹುದು. ಮತ್ತೆ ಪ್ರಯತ್ನಿಸಿ ಅಥವಾ ಹೆಚ್ಚಿನ ಮಾಹಿತಿಗೆ Twitter ಸ್ಥಿತಿಗೆ ಭೇಟಿ ನೀಡಿ.